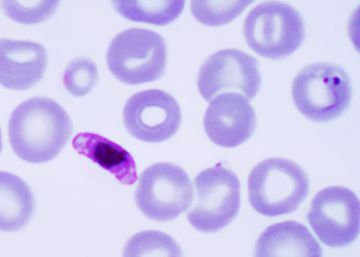
Manipulando genes contra la malaria

Un iceberg como 10 veces Madrid
El calentamiento y el incremento de CO2 condujeron al gigantismo en el Cretácico; será interesante ver si nuestras emisiones reproducen el efecto, como indica una enorme grieta en la Antártida

El calentamiento y el incremento de CO2 condujeron al gigantismo en el Cretácico; será interesante ver si nuestras emisiones reproducen el efecto, como indica una enorme grieta en la Antártida

Los nuevos hallazgos del templo de Göbekli Tepe, en el sur de Turquía, plantean enigmas irresistibles sobre los albores del neolítico

Los avances en la tecnología del ADN nos enfrentan a dilemas de gran importancia para la sociedad; infórmate y entra en el debate

Echar carreras contra la Academia sueca es una estrategia discutible. Y no premiar a más mujeres es un mal plan para el futuro

Miles de buenos científicos dedican su vida a investigar para las grandes firmas farmacéuticas, y las vacunas que han descubierto están en la calle

La píldora que imita al ejercicio está cerca; habrá que ver cuántos ‘runners’ siguen corriendo

Las tecnológicas están convirtiendo nuestra atención en una simple mercancía. Nuestra vida consciente ocupa lugar, y está demasiado expuesta a los cantos de sirena comerciales

La actitud política hacia la homeopatía y otros insultos a la inteligencia es incompatible con un Estado moderno, laico y racional

La presencia de hidrógeno, CO2, metano y fumarolas hidrotermales en Encélado, una modesta luna de Saturno, configura un ambiente similar al que vio nacer la vida en la Tierra

Los efectos de la humanidad sobre la vida animal son tan complejos y sutiles como la tecnología que los sustenta

La muerte de 100.000 chinos al año por la contaminación que generan los productos que venden a Occidente plantea un dilema moral al ciudadano

El último premio Abel revela de nuevo la importancia de esa disciplina para nuestra vida y nuestra comprensión del mundo

El auge de los chamanes se debe a la ignorancia, la desinformación y la avaricia; sin una población que lea libros y periódicos, la democracia está coja y ciega

La reclamación de un gran meteorito por los herederos de quien lo encontró revela la obsolescencia de la ley y la desidia española con su patrimonio científico

Un ensayo inédito del estadista británico y un descubrimiento de la NASA se alían para promover la fuerza de la razón científica

La web SciHub, que ofrece gratis un tesoro de información científica, plantea dudas a los abogados, pero los científicos la apoyan sin fisuras

El mayor problema de salud de la sociedad actual no es el sobrepeso o el alcoholismo: es la pobreza, estúpido

Los nuevos tomates que propone la biotecnología ya no son ni transgénicos: no llevan nada extraño en su genoma. ¿Cuál es el problema entonces?

La investigación confirma que la restricción calórica alarga la vida de los primates y, sobre todo, mejora su calidad en la edad avanzada
Una eficaz vacuna experimental vuelve a revelar la importancia vital de las técnicas transgénicas para la investigación biomédica; y la de mantener una mente abierta

En mitad de la mediocridad política y la inquietud social, 2016 ha producido grandes avances en la física, la biología y la inteligencia artificial

Los científicos logran rejuvenecer a ratones con técnicas de reprogramación inspiradas en las que se usan para obtener células madre. El salto a humanos es una esperanza obvia, pero no inmediata

Un grupo de Barcelona identifica las células del tumor primario que causan las metástasis y la muerte. El trabajo es en ratones, pero promete amplias aplicaciones clínicas en el futuro

Los ministros europeos se cargan su participación en la misión internacional para defendernos de los asteroides. La NASA puede seguir adelante

Degradado hace 10 años a la condición de planeta enano, puede contener más agua que la mismísima Tierra que lo degradó

Una asombrosa secuencia de la BBC sobre una iguana que huye de las serpientes obliga a repensar la comunicación de la ciencia y sus herramientas narrativas

El último premio Nobel de Química ve en el horizonte una de las predicciones más desconocidas del escritor: el nanorrobot cirujano que se inyectará en la sangre

Iberia y Air Europa paralizan una veintena de investigaciones sobre el sufrimiento humano al negarse a transportar animales de laboratorio. Sus argumentos no son sólidos.

El descubrimiento de que los monos fabrican herramientas de piedra se añade a una larga lista de humillaciones que se inició con Copérnico. La humanidad es cada vez menos especial. Por JAVIER SAMPEDRO

Los máximos galardones de la ciencia reconocen descubrimientos en física, química y biología que están creando ahora mismo el mundo de las próximas décadas